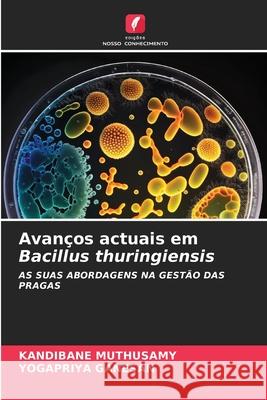
Avanços actuais em Bacillus thuringiensis Muthusamy, Kandibane, GANESAN, YOGAPRIYA 9786202193689

Wyniki wyszukiwania:
wyszukanych pozycji: 67
 |
Gestione degli habitat per conservare i nemici naturali dei parassiti delle colture
ISBN: 9786204883335 / Włoski / Miękka / 60 str. Termin realizacji zamówienia: ok. 10-14 dni roboczych. |
cena:
178,47 |
 |
Gestão do habitat para conservar os inimigos naturais das pragas das culturas
ISBN: 9786204883342 / Portugalski / Miękka / 60 str. Termin realizacji zamówienia: ok. 10-14 dni roboczych. |
cena:
178,47 |
 |
Gestion de l'habitat pour conserver les ennemis naturels des ravageurs des cultures
ISBN: 9786204883311 / Francuski / Miękka / 60 str. Termin realizacji zamówienia: ok. 10-14 dni roboczych. La lutte biologique de conservation implique la manipulation de l'environnement pour améliorer la survie, la fécondité, la longévité et le comportement des ennemis naturels afin d'accroître leur efficacité, de sorte que la population d'insectes nuisibles sur les cultures soit réduite au minimum et maintenue en dessous d'un stade alarmant. Les pratiques de conservation peuvent se concentrer sur la réduction de la mortalité, la fourniture de ressources supplémentaires comme la nourriture, le contrôle des ennemis secondaires, ou la manipulation des attributs de la plante hôte au...
La lutte biologique de conservation implique la manipulation de l'environnement pour améliorer la survie, la fécondité, la longévité et le compor...
|
cena:
178,47 |
 |
Habitat management to conserve natural enemies of pests of crops : Conservation and augmentation of natural enemies of crop pests by habitat manipulation
ISBN: 9786200232113 / Angielski Termin realizacji zamówienia: ok. 10-14 dni roboczych. |
cena:
178,47 |
 |
Habitatmanagement zur Erhaltung der natürlichen Feinde von Kulturpflanzenschädlingen
ISBN: 9786204883298 / Miękka / 60 str. Termin realizacji zamówienia: ok. 10-14 dni roboczych. Bei der biologischen Schädlingsbekämpfung wird die Umwelt manipuliert, um das Überleben, die Fruchtbarkeit, die Langlebigkeit und das Verhalten der natürlichen Feinde zu verbessern, um ihre Wirksamkeit zu erhöhen. Erhaltungsmaßnahmen können sich auf die Verringerung der Sterblichkeit, die Bereitstellung zusätzlicher Ressourcen als Nahrung, die Kontrolle sekundärer Feinde oder die Manipulation von Wirtspflanzeneigenschaften zugunsten der natürlichen Feinde der wichtigsten Formen der biologischen Schädlingsbekämpfung konzentrieren. Manipulation des Ökosystems oder bestehender...
Bei der biologischen Schädlingsbekämpfung wird die Umwelt manipuliert, um das Überleben, die Fruchtbarkeit, die Langlebigkeit und das Verhalten der...
|
cena:
178,47 |
 |
VISIONE E NAVIGAZIONE VISIVA NEGLI INSETTI NOTTURNI
ISBN: 9786206819943 / Włoski / Miękka / 2025 / 128 str. Termin realizacji zamówienia: ok. 10-14 dni roboczych. |
cena:
272,40 |
 |
Transposable elements and evolution of insects
ISBN: 9786206783893 / Angielski / Miękka / 56 str. Termin realizacji zamówienia: ok. 10-14 dni roboczych. Transposable elements are dispersed repeat sequences scattered throughout the genome that are capable to move from one locus to another and replicate themselves in a given genome. These mutagens impact the structure and function of the genome they occupy, but as major components of genomes they have been the principle driving force for their role in evolution with both beneficial as well as negative impacts on the host fitness. The transposable elements provide the potential conditions for the emergence of new genes, modify gene expression, and adaptation to new environmental challenges....
Transposable elements are dispersed repeat sequences scattered throughout the genome that are capable to move from one locus to another and replicate ...
|
cena:
196,36 |
 |
KÜNSTLICHE INTELLIGENZ IN DER SCHÄDLINGSBEKÄMPFUNG
ISBN: 9786208007553 / Niemiecki / Miękka / 2025 / 96 str. Termin realizacji zamówienia: ok. 10-14 dni roboczych. Die Landwirtschaft ist die wichtigste Quelle der indischen Wirtschaft, und etwa 70 Prozent der indischen Landbevölkerung sind für ihren Lebensunterhalt auf die Landwirtschaft angewiesen. Die Landwirtschaft ist einer der Hauptträger des indischen Bruttoinlandsprodukts. Schädlinge spielen eine große Rolle bei der Verringerung der Produktivität, mehr als 35 % der Produktivität wurde durch verschiedene Schädlinge verringert. Künstliche Intelligenz (KI) und maschinelles Lernen fördern nachhaltige und effektive Lösungen für ein breites Spektrum von landwirtschaftlichen Problemen. Die...
Die Landwirtschaft ist die wichtigste Quelle der indischen Wirtschaft, und etwa 70 Prozent der indischen Landbevölkerung sind für ihren Lebensunterh...
|
cena:
272,40 |
 |
GALL INDUCING INSECTS: FROM ANATOMY TO BIODIVERSITY AND MANAGEMENT
ISBN: 9786208436148 / Angielski / Miękka / 2025 / 84 str. Termin realizacji zamówienia: ok. 10-14 dni roboczych. Galls represent a fascinating natural phenomenon reflecting intimate interactions between organisms that have been shaped by organic evolution throughout millions of years. Approximately 13,000 species of insect gallers known in the world. Galls inducers have evolved independently in six orders of insects namely, Thysanoptera, Hemiptera, Lepidoptera, Coleoptera, Diptera, and Hymenoptera. Galls can be induced by a wide variety of organisms namely viruses, bacteria, fungi, algae, nematodes, copepods, and plants from the family Loranthaceae but are mainly caused by insects. The species richness...
Galls represent a fascinating natural phenomenon reflecting intimate interactions between organisms that have been shaped by organic evolution through...
|
cena:
196,36 |
 |
ATTUALI AVANZAMENTI NEL BACILLUS THURINGIENSES
ISBN: 9786202193337 / Włoski / Miękka / 2025 / 96 str. Termin realizacji zamówienia: ok. 10-14 dni roboczych. |
cena:
196,36 |
 |
BIE ACE POST PY W BAKTERIACH Bacillus thuringiensis
ISBN: 9786202193528 / Polski / Miękka / 2025 / 96 str. Termin realizacji zamówienia: ok. 10-14 dni roboczych. |
cena:
196,36 |
 |
INSECTOS INDUTORES DE GALHAS: DA ANATOMIA À BIODIVERSIDADE E À GESTÃO
ISBN: 9783639723014 / Portugalski / Miękka / 2025 / 76 str. Termin realizacji zamówienia: ok. 10-14 dni roboczych. |
cena:
196,36 |
 |
GALLEVERURSACHENDE INSEKTEN: VON DER ANATOMIE ZUR BIODIVERSITÄT UND ZUM MANAGEMENT
ISBN: 9783639722925 / Niemiecki / Miękka / 2025 / 80 str. Termin realizacji zamówienia: ok. 10-14 dni roboczych. Gallen sind ein faszinierendes Naturphänomen, das die intimen Interaktionen zwischen Organismen widerspiegelt, die im Laufe der Jahrmillionen durch die organische Evolution geprägt wurden. Weltweit sind etwa 13.000 Arten von Insektengallen bekannt. Gallen haben sich unabhängig voneinander in sechs Insektenordnungen entwickelt: Thysanoptera, Hemiptera, Lepidoptera, Coleoptera, Diptera und Hymenoptera. Gallen können durch eine Vielzahl von Organismen ausgelöst werden, nämlich Viren, Bakterien, Pilze, Algen, Nematoden, Copepoden und Pflanzen aus der Familie der Loranthaceae, werden aber...
Gallen sind ein faszinierendes Naturphänomen, das die intimen Interaktionen zwischen Organismen widerspiegelt, die im Laufe der Jahrmillionen durch d...
|
cena:
196,36 |
 |
SEHEN UND VISUELLE NAVIGATION BEI NACHTAKTIVEN INSEKTEN
ISBN: 9786206819912 / Niemiecki / Miękka / 2025 / 132 str. Termin realizacji zamówienia: ok. 10-14 dni roboczych. Trotz ihrer geringen Größe und der begrenzten Anzahl von Neuronen verfügen Insekten über ein hochentwickeltes Sehsystem. Ihre Facettenaugen ermöglichen es ihnen, eine Vielzahl von Aufgaben zu erfüllen, wie z. B. das Auffinden von Nahrung, das Ausweichen vor Raubtieren und das Navigieren in komplexen Umgebungen. Nachtaktive Insekten müssen sich zusätzlich der Herausforderung stellen, bei schlechten Lichtverhältnissen zu agieren, die bis zu 11 Größenordnungen schwächer sein können als das Tageslicht. Trotz dieser schwierigen Bedingungen haben nachtaktive Insekten festgestellt, dass...
Trotz ihrer geringen Größe und der begrenzten Anzahl von Neuronen verfügen Insekten über ein hochentwickeltes Sehsystem. Ihre Facettenaugen ermög...
|
cena:
272,40 |
 |
ARTIFICIAL INTELLIGENCE IN INSECT PESTS MANAGEMENT
ISBN: 9786208442965 / Angielski / Miękka / 2025 / 108 str. Termin realizacji zamówienia: ok. 10-14 dni roboczych. Agriculture is the main source of the Indian economy and about 70 per cent of India's rural population is dependent on agriculture for their livelihood. Agriculture is one of the main contributors to the Gross Domestic Product in India. Pest plays a great impact in decreasing the productivity, more than 35 % of productivity had decreased by different pest. Artificial Intelligence (A. I.) and Machine learning are fostering more sustainable and effective solutions for a wide spectrum of agricultural problems. Pest management is a major challenge for crop production that can benefit from machine...
Agriculture is the main source of the Indian economy and about 70 per cent of India's rural population is dependent on agriculture for their livelihoo...
|
cena:
272,40 |
 |
Evolutionsgeschichte der Bienenstöcke
ISBN: 9786204327211 / Niemiecki / Miękka / 72 str. Termin realizacji zamówienia: ok. 10-14 dni roboczych. Die Bienenzucht ist eine der am weitesten verbreiteten landwirtschaftlichen Tätigkeiten, die überall auf der Welt praktiziert wird. Der Bau von Bienenstöcken variiert von Region zu Region. Der traditionelle Bienenstock entstand in dem Bestreben, die billigen und reichlich vorhandenen lokalen Materialien für den Bienenstockbau zu nutzen. Moderne Bienenstöcke hingegen haben ein kastenförmiges Gehäuse mit abnehmbarem Deckel oder Rähmchen, die die Kontrolle der Bienenvölker durch den Arbeitsweg erleichtern. Aufgrund der Notwendigkeit, die Bienenstöcke zu manipulieren, um den ständig...
Die Bienenzucht ist eine der am weitesten verbreiteten landwirtschaftlichen Tätigkeiten, die überall auf der Welt praktiziert wird. Der Bau von Bien...
|
cena:
245,56 |
 |
SZTUCZNA INTELIGENCJA W ZWALCZANIU SZKODNIKÓW OWADZICH
ISBN: 9786208007584 / Polski / Miękka / 2025 / 96 str. Termin realizacji zamówienia: ok. 10-14 dni roboczych. |
cena:
272,40 |
 |
INTELIGÊNCIA ARTIFICIAL NA GESTÃO DAS PRAGAS DE INSECTOS
ISBN: 9786208007607 / Portugalski / Miękka / 2025 / 96 str. Termin realizacji zamówienia: ok. 10-14 dni roboczych. |
cena:
272,40 |
|
Avanços actuais em Bacillus thuringiensis
ISBN: 9786202193689 / Portugalski / Miękka / 2025 / 96 str. Termin realizacji zamówienia: ok. 10-14 dni roboczych. |
cena:
196,36 |
 |
INSECTES INDUCTEURS DE GALLE : DE L'ANATOMIE À LA BIODIVERSITÉ ET À LA GESTION
ISBN: 9783639722970 / Francuski / Miękka / 2025 / 80 str. Termin realizacji zamówienia: ok. 10-14 dni roboczych. Les galles représentent un phénomène naturel fascinant reflétant les interactions intimes entre les organismes qui ont été façonnés par l'évolution organique au cours de millions d'années. On connaît environ 13 000 espèces d'insectes gallers dans le monde. Les inducteurs de galles ont évolué indépendamment dans six ordres d'insectes, à savoir les thysanoptères, les hémiptères, les lépidoptères, les coléoptères, les diptères et les hyménoptères. Les galles peuvent être induites par une grande variété d'organismes, à savoir des virus, des bactéries, des...
Les galles représentent un phénomène naturel fascinant reflétant les interactions intimes entre les organismes qui ont été façonnés par l'évo...
|
cena:
196,36 |











